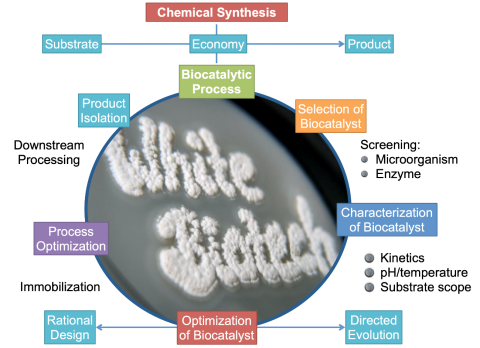
Biocatalysis

HOMOGENEOUS CATALYSIS
Catalysts control and accelerate nearly all chemical and biochemical reactions without appearing in the final product. Chemists refer to homogeneous catalysis when all reactants involved in the process are in the same physical state, most commonly as a solution in the liquid phase.
A classic catalytically influenced process is alcoholic fermentation from sugar, first practiced by the Sumerians around 8,000 years ago in Mesopotamia.
The lead chamber process by Desormes and Clément (1806) is considered the first technical procedure for producing a bulk chemical sulfuric acid. Enzyme catalysis dates back to the early 20th century, with examples like the enzymatic cleavage of sucrose into glucose and fructose. Today, enzyme catalysis underpins the resource-efficient production of pharmaceuticals, fine chemicals, vitamins, and detergents.
Homogeneous catalysts often involve transition metals, named for their position in the periodic table. The reactive metal center is typically embedded in a molecular framework, called a ligand, which also influences key parameters of the reaction, such as turnover or selectivity.
Historically, homogeneous catalysis developed as the "workhorse" of organic chemistry, which is carbon-based and predominantly product-oriented. Among its advantages over heterogeneous catalysis are milder reaction conditions (lower pressures and moderate temperatures) and higher selectivity, which leads to fewer side products. However, recovery of the catalyst after the reaction remains a challenge.
Today, the previously rigid boundary between homogeneous and heterogeneous catalysis is increasingly blurred. Modern research reflects this convergence, especially as inorganic chemistry, more analytical and theory-driven, contributes to the understanding of catalytic mechanisms across both domains.